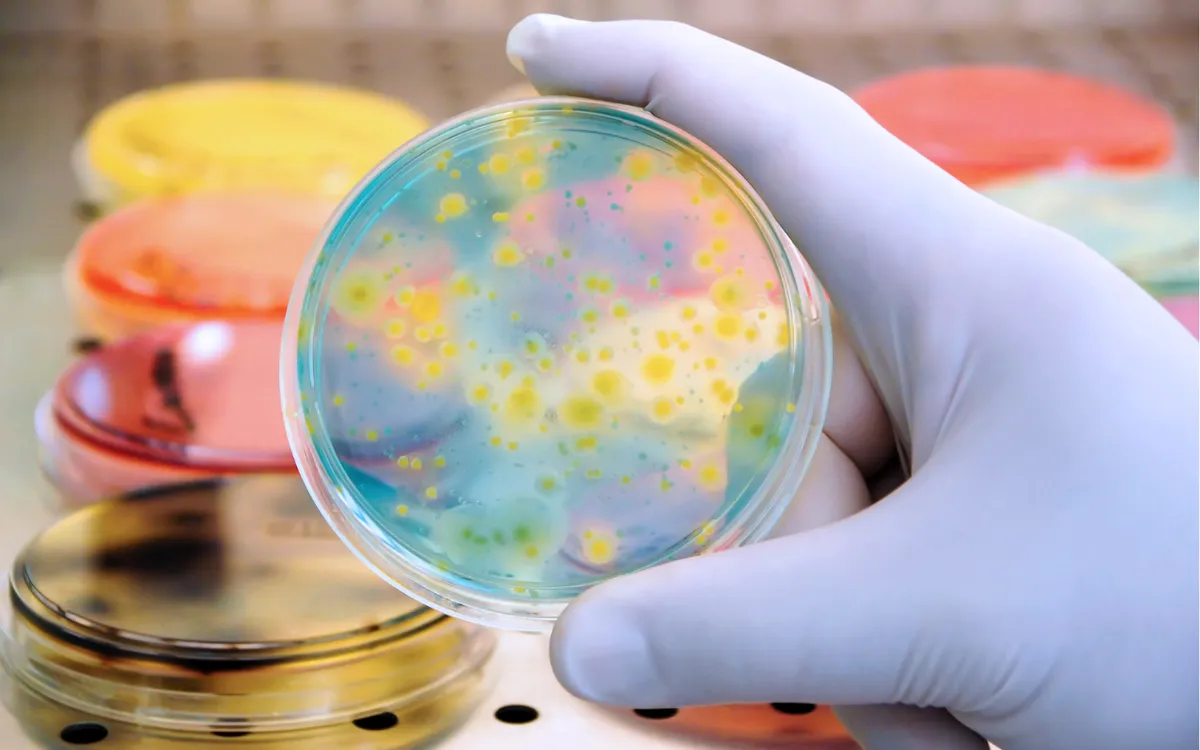

Chị N.T.H. (20 tuổi, sống tại Hà Nội) được bạn trai thông báo rằng, anh ấy bị nhiễm lậu và đã điều trị khỏi. Dù chưa có triệu chứng của bệnh như: tiết dịch âm đạo bất thường, tiểu buốt, tiểu rắt… nhưng lo lắng cho sức khỏe, chị H. đã chủ động đến văn phòng lấy mẫu của Medlatec gần nhà để làm xét nghiệm tầm soát các bệnh lây truyền qua đường tình dục.
Kết quả xét nghiệm vi khuẩn Real-time PCR hệ thống tự động (4 tác nhân gây bệnh đường tình dục thường gặp) cho thấy, chị H. dương tính với vi khuẩn lậu (CT 20,45).
Ngay khi có kết quả xét nghiệm, nhân viên y tế đã gọi điện tư vấn và hướng dẫn chị H. cùng bạn trai đến bệnh viện để được thăm khám và điều trị.
Qua khám bệnh, kết hợp với kết quả xét nghiệm PCR dương tính, bác sĩ chẩn đoán chị mắc viêm âm đạo do lậu. Bệnh nhân được kê đơn thuốc, điều trị ngoại trú và hẹn ngày tái khám.
Trường hợp này cho thấy, việc chủ động xét nghiệm sau khi có yếu tố nguy cơ, dù chưa có triệu chứng rõ ràng là vô cùng cần thiết để bảo vệ sức khỏe bản thân và cộng đồng.

Bệnh lậu – Căn bệnh lây truyền qua đường tình dục rất phổ biến và nguy hiểm
Bệnh lậu là một trong những bệnh lây truyền qua đường tình dục hay gặp, do song cầu khuẩn Gram âm Neisseria gonorrhoeae gây ra.
Thời gian ủ bệnh ở nam giới trung bình từ 3-5 ngày. Ở nữ giới thời gian ủ bệnh thường kéo dài hơn, trung bình 5-7 ngày. Thời gian này, dù người bệnh không có triệu chứng nhưng vẫn có khả năng lây lan cho người khác.
Bệnh lây truyền qua 4 con đường:
Quan hệ tình dục không an toàn (âm đạo, hậu môn, miệng); Tiếp xúc trực tiếp với dịch tiết từ người nhiễm (tinh dịch, dịch âm đạo); Từ mẹ sang con trong lúc sinh thường (trẻ có thể viêm kết mạc mắt); Dùng chung đồ dùng cá nhân như khăn tắm, đồ lót.
Các triệu chứng của bệnh:
Ở nam giới:
Tiểu buốt, tiểu rắt, tiểu ra mủ màu vàng/ xanh; Đau khi quan hệ tình dục hoặc xuất tinh; Sưng, đau tinh hoàn (trường hợp nặng).
Ở nữ giới:
Tiết dịch âm đạo bất thường; Đau rát khi tiểu tiện; Chảy máu giữa chu kỳ hoặc sau quan hệ.
Lưu ý: Nữ giới thường không có triệu chứng rõ ràng, dễ bỏ sót và dẫn đến biến chứng.
Triệu chứng khác nếu nhiễm ở vị trí không sinh dục:
Hậu môn: ngứa, tiết dịch, đau rát hậu môn. Họng: viêm họng, nuốt đau. Mắt: đỏ, chảy mủ, đau mắt.
Biến chứng nguy hiểm của bệnh:
Đối với nam giới, nhiễm lậu nếu không được điều trị có thể dẫn đến viêm mào tinh hoàn, hẹp niệu đạo và vô sinh. Nguy cơ biến chứng tăng lên khi bị tái nhiễm nhiều lần.
Ở nữ giới, nhiễm lậu có thể dẫn đến các biến chứng nghiêm trọng như: viêm tiểu khung, viêm nội mạc tử cung, viêm vòi trứng và áp xe vòi trứng, chửa ngoài tử cung và vô sinh.
Riêng với trẻ sơ sinh, viêm kết mạc mắt do lậu có biểu hiện chảy mủ ở mắt và sưng mí mắt. Nếu không được điều trị, trẻ có thể bị loét, sẹo giác mạc và mù.
Bác sĩ khuyến cáo, để phòng bệnh lậu, các cặp đôi cần thực hiện quan hệ tình dục an toàn (sử dụng bao cao su đúng cách); không dùng chung đồ cá nhân; xét nghiệm định kỳ nếu có nhiều bạn tình; phụ nữ mang thai cần sàng lọc lậu để phòng lây cho con. Đặc biệt, nếu nghi ngờ hoặc có các yếu tố nguy cơ của bệnh, cần đến ngay các cơ sở y tế để được thăm khám và điều trị kịp thời.


Bình luận (0)